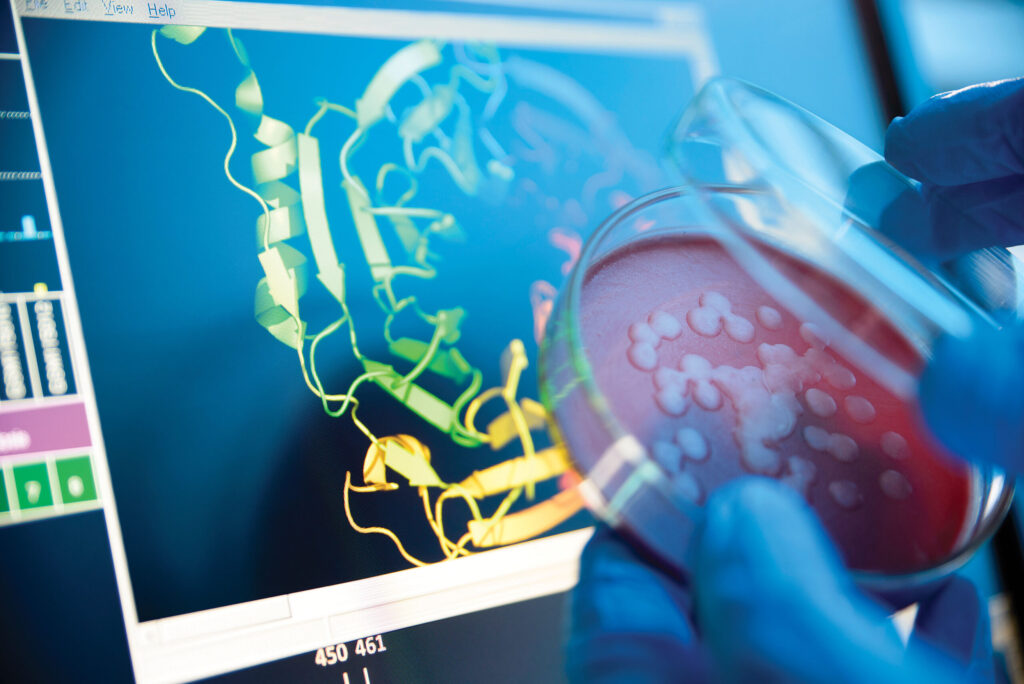

Biotechnology is a neo-scientific discipline that uses living organisms to acquire valuable products and processes. It merges biological science and engineering science to solve real-world challenges. From healthcare to farming, it is reshaping industries. Scientists use cells, enzymes, and DNA to produce new solutions. The international biotechnology securities industry is growing in an efficient way, valued at over $1 cardinal. It plays a vital role in improving health, increasing food production, and protecting the world.
Account and Development of Biotechnology:
The roots of biotechnology go back thousands of years. Retrospectively, early humanity used yeast to make bread and intoxicants through fermentation. In 1928, Alexander the Great Fleming discovered penicillin, the first antibiotic drug was made by using microorganisms. So, a major turning point came in the 1970s with the discovery of recombinant DNA engineering science. This finding allowed scientists to mix genes from divergent organisms. The Human Genome Project, accomplished in 2003, mapped human DNA and started new possibilities. Today, it includes fields like genetic engineering, molecular biology, and agglutinative biological science.
Applications in medicine:

Medical exam Biotechnology has changed healthcare by offering targeted therapies and high-tech nosology. So, it enables the development of vaccines, gene therapies, and personalized medication. For a deterrent example, insulin for diabetes is now made using genetically engineered bacteria. Monoclonal antibodies are used to treat cancer, the crab, and autoimmune diseases. CRISPR, a gene-editing tool, can possibly cure inheritable disorders. Historically, COVID-19 vaccines like Pfizer and Moderna were highly developed using biotech platforms. These innovations help doctors name diseases in the beginning and treat them more effectively.
Agrarian Biotechnology:
Agrarian Biotechnology helps farmers grow more food with fewer resources. Genetically adapted crops like corn and soybeans defy pests and require less pesticide. Drought-tolerant varieties allow cultivation in dry areas. Fortunate Rice, enriched with vitamin A, helps forestall sightlessness in children. Farm animals can be bred for disease resistance and improved productivity. According to the FAO, international food involvement will rise by 70% by 2050. It helps meet that need while reducing environmental shock.
Environmental Biotechnology:

Environmental biotechnology focuses on cleaning up waste and protecting the natural state. Microbes are used to break down oil spills, plastics, and toxic waste. Bioreactors treat effluent and get clean water from slime. Bioremediation methods spruce up contaminated soil and groundwater. Algae can suck carbon dioxide and get biofuels. Green bio-tech promotes sustainable practices and reduces chemical use. These technologies help build a cleaner, better satellite, and bread-and-butter environmental preservation.
Highly developed biotechnology:
Highly developed Biotechnology uses living cells and enzymes to produce eco-compassionate products. It replaces calumniatory chemicals with bastardly processes. Enzymes are used in detergents to clean wearing apparel at lower temperatures. Bioplastics made from corn or sugar cane abridge befoulment. Biofuels like ethyl alcohol and biodiesel are cleaner alternatives to fossil fuels. According to the OECD, industrialized biotech could abridge international CO₂ emissions by 2.5 cardinal tons by 2030. It promotes a round economic system and supports green industries.
Biotechnology in Ordinary Life:
Biotechnology is part of many things we use every day. Yogurt and cheese are made with bacteria and enzymes. Biotech ingredients are found in shampoos, lotions, and vitamins. DNA testing kits use it to search for blood and health traits. Even perishable packaging and plant-based meats are biotech innovations. This scientific discipline powers many behind-the-scenes processes that ameliorate contraption health and sustainability in daily life.
Honorable and Cultural Considerations:
With great power comes great responsibility, and biotechnology raises various honorable issues. Heritable engineering in humanity sparks consideration about house decorator babies. Cloning and fleshly testing raise concerns about fleshly rights and welfarism. GMOs are debated for their shock on health and the surroundings. Storing genetic data in health check databases also raises secrecy concerns. Governments and organizations produce rules to see that biotech is used safely and ethically. World pedagogy is, in essence, to turn to fears and boost well-read decisions.
Origin of Biotechnology:

The hereafter of biotechnology is full of exciting possibilities. Individualized medication will tailor-make treatments to separate genes and lifestyles. Plum farming and modified crops will help in feeding growing populations. Scientists are developing lab-grown meat to abridge fleshly farming. AI and automobile learning are improving inquiry and speeding up discoveries. It could even help overthrow aging or cure cancer, the crab. As we face international challenges, biotech will play a decisive role in building an amended hereafter.
Conclusion:
Biotechnology is more than a scientific discipline—it’s a reigning tool for passing on. From health breakthroughs to sustainable solutions, it touches every part of life. So, its role in shaping the hereafter is incontrovertible. With continuing excogitation and honorable inadvertence, biotechnology will keep transforming the world.